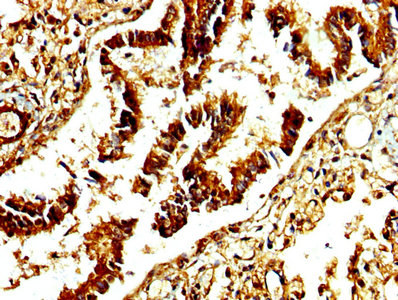
CSB-PA001311LA01HU

ADAMTS4
ADAMTS4蛋白全稱為整合素樣金屬蛋白酶與血小板反應蛋白基序4,常被稱為Aggrecanase-1或ADMP-1。該蛋白在維持細胞外基質動態平衡中起關鍵作用,能夠特異性分解軟骨組織中的核心成分aggrecan,這種特性使其成為關節退行性疾病的重要研究靶點。在骨關節炎和類風濕性關節炎患者體內,其異常活躍的酶切活性會加速軟骨基質破壞,導致關節結構塌陷和功能喪失。ADAMTS4在腫瘤微環境中同樣扮演著特殊角色,可能通過重塑細胞外基質促進癌細胞侵襲轉移,特別是在乳腺癌和膠質瘤中觀察到其表達水平與疾病進展密切相關。
針對ADAMTS4的藥物開發主要聚焦于選擇性抑制劑研究,已有多個小分子化合物進入臨床前試驗階段,通過阻斷其酶活性來減緩軟骨退化進程。其中部分黃酮類衍生物在動物模型中顯示出保護關節軟骨的效果,而基于單克隆抗體的靶向療法也取得突破性進展。值得關注的是,某些已上市的抗炎藥物被發現具有間接調控該蛋白活性的潛能,這為老藥新用開辟了新方向。目前相關研究正在探索其在神經退行性疾病中的應用價值,特別是阿爾茨海默病中淀粉樣斑塊的形成可能與ADAMTS4介導的蛋白水解過程存在關聯。
熱銷產品
驗證數據

(Tris-Glycine gel) Discontinuous SDS-PAGE (reduced) with 5% enrichment gel and 15% separation gel.
ADAMTS4 Antibody (CSB-PA001311LA01HU)
驗證數據

Immunohistochemistry of paraffin-embedded human heart tissue using CSB-PA001311LA01HU at dilution of 1:100

Western Blot
Positive WB detected in: Mouse kidney tissue
All lanes: ADAMTS4 antibody at 3.2µg/ml
Secondary
Goat polyclonal to rabbit IgG at 1/50000 dilution
Predicted band size: 91 kDa
Observed band size: 91 kDa

Immunohistochemistry of paraffin-embedded human liver tissue using CSB-PA001311LA01HU at dilution of 1:100
IHC image of CSB-PA001311LA01HU diluted at 1:250 and staining in paraffin-embedded human lung tissue performed on a Leica BondTM system. After dewaxing and hydration, antigen retrieval was mediated by high pressure in a citrate buffer (pH 6.0). Section was blocked with 10% normal goat serum 30min at RT. Then primary antibody (1% BSA) was incubated at 4°C overnight. The primary is detected by a biotinylated secondary antibody and visualized using an HRP conjugated SP system.
Human ADAM metallopeptidase with thrombospondin type 1 motif4,ADAMTS4 ELISA Kit (CSB-E11848h)
驗證數據

貨號:CSB-E11848h
規格:96T/48T
靈敏度:3.125 ng/ml
檢測范圍:12.5 ng/ml - 800 ng/ml
These standard curves are provided for demonstration only. A standard curve should be generated for each set of samples assayed.
ADAMTS4 Antibodies
ADAMTS4 for Homo sapiens (Human)
| 產品貨號 | 產品名稱 | 種屬反應性 | 應用類型 |
|---|---|---|---|
| CSB-PA001311LA01HU | ADAMTS4 Antibody | Human, Mouse | ELISA, WB, IHC |
| CSB-PA001311LB01HU | ADAMTS4 Antibody, HRP conjugated | Human | ELISA |
| CSB-PA001311LC01HU | ADAMTS4 Antibody, FITC conjugated | Human | |
| CSB-PA001311LD01HU | ADAMTS4 Antibody, Biotin conjugated | Human | ELISA |
ADAMTS4 Proteins
ADAMTS4 Proteins for Homo sapiens (Human)
| 產品貨號 | 產品名稱 | 來源 |
|---|---|---|
| CSB-YP001311HU CSB-EP001311HU CSB-BP001311HU CSB-MP001311HU CSB-EP001311HU-B |
Recombinant Human A disintegrin and metalloproteinase with thrombospondin motifs 4 (ADAMTS4) | Yeast E.coli Baculovirus Mammalian cell In Vivo Biotinylation in E.coli |
| CSB-EP001311HU1 | Recombinant Human A disintegrin and metalloproteinase with thrombospondin motifs 4 (ADAMTS4), partial | E.coli |
ADAMTS4 ELISA Kit
ADAMTS4 ELISA Kit for Homo sapiens (Human)
| 產品貨號 | 產品名稱 | 樣本類型 | 靈敏度 |
|---|---|---|---|
| CSB-E11848h | Human ADAM metallopeptidase with thrombospondin type 1 motif4,ADAMTS4 ELISA Kit | serum, plasma, tissue homogenates | 3.125 ng/ml |














